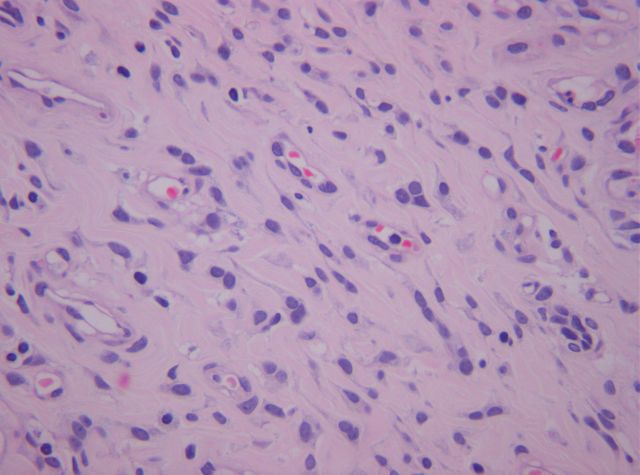

|
Angiomiofibroblastoma de vagina Lluís E. Pons Ferre*, Tomás Álvaro Naranjo**, Joaquín Jaén Martínez***, Ramon Bosch Príncep****, Carmen Mateo*****, Marylène Lejeune****, Teresa Salvadó Usach******, Carlos López Pablo**** |
||||||||||||||||||||||||||||||||||||||||||
|
Angiomiofibroblastoma de vagina. Lluís E. Pons, Joaquín Jaén, Ramon Bosch, Carmen Mateo(1), Marylène Lejeune, Teresa Salvadó, Carlos López, Tomás Álvaro. Servicios de Patología y Ginecología(1), Hospital de Tortosa Verge de la Cinta. Tortosa. El angiomiofibroblastoma es una entidad rara, benigna, de estirpe mesenquimal, descrita recientemente. Con mayor frecuencia se describe en mujeres y localizado en región vulvovaginal; aunque existen recogidas en la literatura otras localizaciones anatómicas y casos descritos en varones. Presentamos el caso de una mujer de 63 años con un nódulo único situado en cara lateral izquierda del tercio superior de vagina, de 2 cm de tamaño, pediculado, no dolorosa al tacto y que se extirpa para posterior análisis anatomopatológico cuyo diagnóstico es de angiomiofibroblastoma de vagina. Se describe una proliferación celular de tipo mesenquimal, con densidad celular moderada y patrón celular en forma de haces entremezclados con tejido fibroconjuntivo y fondo levemente mixoide. A nivel celular se observa núcleos de pequeño tamaño con hipercromasia moderada y de morfología ovalada o fusiforme. No se observa pleomorfismo celular ni atipicidad. Presencia de abundantes estructuras capilares. El estudio inmunofenotípico pone de relieve positividad sobre la celularidad proliferante para filamentos intermedos de Vimentina y focalmente de Desmina, poniendo de manifiesto la tinción para Actina las numerosas estructuras vasculares; negatividad para citoqueratinas y CD34. El principal diagnóstico diferencial a realizar es con el angiomixoma agresivo, del que se puede distinguir porque el angiomiofibroblastoma muestra contornos circunscritos, mayor celularidad y mayor presencia vascular sin engrosamiento de la pared de dichas estructuras; la celularidad estromal del angiomiofibroblastoma muestra mayor citoplasma con un cierto hábito epitelioide-plasmocitoide, mínima presencia de mucinosis estromal y raramente extravasación hemática.
|
|||||||||||||||||||||||||||||||||||||||||||
|
|
El angiomiofibroblastoma es una entidad rara, benigna, de estirpe mesenquimal. Presentamos el caso de una mujer de 63 años con un nódulo único situado en cara lateral izquierda del tercio superior de vagina, de 2 cm de tamaño, pediculado, no doloroso al tacto y que se extirpa para posterior análisis anatomopatológico.
|
||||||||||||||||||||||||||||||||||||||||||
|
|
Se recibe en nuestro laboratorio de Patología un fragmento irregular de coloración violácea que mide 18 mm de diámetro máximo. En el estudio histopatológico se describe una proliferación celular de tipo mesenquimal, con densidad celular moderada y patrón celular en forma de haces entremezclados con tejido fibroconjuntivo y fondo levemente mixoide. A nivel celular se observa núcleos de pequeño tamaño con hipercromasia moderada y de morfología ovalada o fusiforme. No se observa pleomorfismo celular ni atipicidad. Presencia de abundantes estructuras capilares. El estudio inmunofenotípico pone de relieve positividad sobre la celularidad proliferante para filamentos intermedios de Vimentina y focalmente de Desmina, poniendo de manifiesto la tinción para Actina las numerosas estructuras vasculares; negatividad para citoqueratinas y CD34. El diagnóstico efectuado es de angiomiofibroblastoma de vagina.
|
||||||||||||||||||||||||||||||||||||||||||
|
|
El angiomiofibroblastoma es una entidad descrita recientemente por Fletcher y colaboradores. Con mayor frecuencia, se describe en mujeres y localizada en la región vulvovaginal; aunque existen recogidas en la literatura otras localizaciones anatómicas y casos descritos en varones. Microscópicamente se caracteriza por tratarse de una lesión estromal bien delimitada, rodeada variablemente de tejido fibroso compresivo. En su interior es inusual observar atrapadas estructuras nerviosas o epiteliales glandulares. La celularidad estromal se distribuye arquitecturalmente de forma heterogénea en áreas hipocelulares alternadas con áreas hipercelulares; entremezclada entre la celularidad estromal, se localizan abundantes formaciones vasculares de paredes finas y delicadas (algunas con ocasional fenómeno de esclerosis alrededor) que caracterizan la lesión. La celularidad estromal está formada a expensas de células de hábito plasmocitoide y fusiforme, con núcleos ovalados, sin criterios de atipia. Puede observarse alguna célula multinucleada. La matriz estromal está compuesta a partir de material colágeno, con la posibilidad de producirse entre las fibras edema o depósito de material mucinoso. El patrón inmunohistoquímico que caracteriza esta lesión es positivo para vimentina, desmina poniéndose así de manifiesto su naturaleza miofibroblástica- y negativo para actina, así como otros marcadores estromales. Los principales diagnósticos diferenciales a plantearse son con el angiomixoma agresivo y con el angiofibroma celular (ver tablas adjuntas); otros diagnósticos diferenciales a tener en cuenta son el leiomioma epiteliode mixoide, el tumor glómico, el angiomixoma superficial, el tumor de la vaina nerviosa y entidades malignas como el histiocitoma fibroso maligno y el liposarcoma mixoide.
|
||||||||||||||||||||||||||||||||||||||||||
|
|
El angiomiofibroblastoma es una lesión nodular, pediculada e indolora habitualmente localizada en la región vulvovaginal. Histológicamente representa un nuevo tipo de lesión en el amplio espectro de tumores y condiciones tumor-like en los cuales los miofibroblastos constituyen su componente integral. El estudio inmunohistoquímico para la determinación de fibras de Desmina es de ayuda en el diagnóstico. Su tratamiento es la escisión simple y no muestra recidivas. Debe considerársele como una entidad diferente del angiomixoma agresivo a la vista de su naturaleza benigna.
|
||||||||||||||||||||||||||||||||||||||||||
|
|
-Iwasa Y, Fletcher CD.Cellular angiofibroma: clinicopathologic and immunohistochemical analysis of 51 cases. Am J Surg Pathol. 2004 Nov;28(11):1426-35.
-Mc Cluggage WG, White RG. Angiomyofibroblastoma of the vagina.J Clin Pathol. 2000 Oct;53(10):803. -Laskin WB, Fetsch JF, Tavassoli FA. Angiomyofibroblastoma of the female genital tract: analysis of 17 cases including a lipomatous variant. Hum Pathol. 1997 Sep;28(9):1046-55. -Fukunaga M, Nomura K, Matsumoto K, Doi K, Endo Y, Ushigome. Vulval angiomyofibroblastoma. Clinicopathologic analysis of six cases. Am J Clin Pathol. 1997 Jan;107(1):45-51. -Nielsen GP, Rosenberg AE, Young RH, Dickersin GR, Clement PB, Scully RE. Angiomyofibroblastoma of the vulva and vagina.Mod Pathol. 1996 Mar;9(3):284-91. -Hisaoka M, Kouho H, Aoki T, Daimaru Y, Hashimoto H. Angiomyofibroblastoma of the vulva: a clinicopathologic study of seven cases.Pathol Int. 1995 Jul;45(7):487-92. -Hiruki T, Thomas MJ, Clement PB. Vulvar Angiomyofibroblastoma. Am J Surg Pathol. 1993 Apr;17(4):423-4. -Fletcher CD, Tsang WY, Fisher C, Lee KC, Chan JK. Angiomyofibroblastoma of the vulva. A benign neoplasm distinct from aggressive angiomyxoma. Am J Surg Pathol. 1992 Apr;16(4):373-82.
|
||||||||||||||||||||||||||||||||||||||||||
|
|
- Manuel Diaz-Marta Puentes (21/01/2012 2:18:15)
- Manuel Diaz-Marta Puentes (21/01/2012 2:18:16)
- Manuel Diaz-Marta Puentes (21/01/2012 2:18:16)
|
||||||||||||||||||||||||||||||||||||||||||
|
|
|
Web mantenido y actualizado por el Servicio de informática uclm. Modificado: 16/06/2015 15:10:50
 fiogf49gjkf0dSe observa una lesión nodular, pediculada, de aproximadamente 2 cm de diámetro máximo.">
fiogf49gjkf0dSe observa una lesión nodular, pediculada, de aproximadamente 2 cm de diámetro máximo.">
 fiogf49gjkf0dAbundantes estructuras capilares de paredes finas y delicadas.">
fiogf49gjkf0dAbundantes estructuras capilares de paredes finas y delicadas.">
 fiogf49gjkf0dProliferación mesenquimal, sin rasgos citológicos de atipia celular; matriz estromal fibroconjuntiva.">
fiogf49gjkf0dProliferación mesenquimal, sin rasgos citológicos de atipia celular; matriz estromal fibroconjuntiva.">
 fiogf49gjkf0dEl Angiomiofibroblastoma muestra áreas de hipocelularidad estromal alternadas con otras hipercelulares (ver fotografía siguiente).">
fiogf49gjkf0dEl Angiomiofibroblastoma muestra áreas de hipocelularidad estromal alternadas con otras hipercelulares (ver fotografía siguiente).">
 fiogf49gjkf0dÁreas de densidad celular aumentada.">
fiogf49gjkf0dÁreas de densidad celular aumentada.">
fiogf49gjkf0dCelularidad miofibroblástica de hábito plasmocitoie y fusiforme.">
fiogf49gjkf0dCelularidad miofibroblástica de hábito plasmocitoie y fusiforme.">
 fiogf49gjkf0dAbundantes estructuras vasculares de pequeño tamaño, de paredes finas, que derminan el segundo componente de la lesión.">
fiogf49gjkf0dAbundantes estructuras vasculares de pequeño tamaño, de paredes finas, que derminan el segundo componente de la lesión.">
 fiogf49gjkf0dTendencia de la celularidad estromal miofibroblástica de distribuirse alrededor de los vasos.">
fiogf49gjkf0dTendencia de la celularidad estromal miofibroblástica de distribuirse alrededor de los vasos.">
 fiogf49gjkf0dPositividad difusa para la determinacióm inmunohistoquímica de Vimentina.">
fiogf49gjkf0dPositividad difusa para la determinacióm inmunohistoquímica de Vimentina.">
 fiogf49gjkf0dPositividad en la determinación inmunohistoquímica de fibras de Desmina que pone de relievo la estirpe miofibroblástica de la lesión.">
fiogf49gjkf0dPositividad en la determinación inmunohistoquímica de fibras de Desmina que pone de relievo la estirpe miofibroblástica de la lesión.">